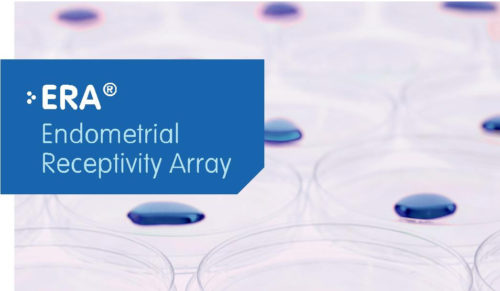
ERA 05

Mnogim parovima koji imaju problema da se prirodnim putem ostvare kao roditelji, jedina opcija je vantjelesna oplodnja. Nažalost, ova metoda ne samo da je skup proces, već nekada iziskuje dva ili više pokušaja.
Mnogim parovima koji imaju problema da se prirodnim putem ostvare kao roditelji, jedina opcija je vantjelesna oplodnja. Nažalost, ova metoda ne samo da je skup proces, već nekada iziskuje dva ili više pokušaja.
Zahvaljući novom ERA testu endometrijalne prijemčivosti, to više ne bi trebalo da predstavlja problem. Prema kliničkim ispitivanjima, ovaj test donosi uspjeh kod preko 80 odsto kod žena koje su imale jedan ili više neuspjelih postupaka vantjelesne oplodnje, kao i kod žena koje prvi put ulaze u postupak liječenja steriliteta kako bi značajno povećale šanse, nakon prvog pokušaja vantjelesne oplodnje.
ERA test je uveo i značajno povećanje procenta uspješnosti vantjelesne oplodnje kod svih starosnih grupa.
Riječ je o savremenoj dijagnostici koju je razvila i patentirala prestižna španska genetska laboratorija IGENOMIX sa čuvenim profesorom Karlosom Simonom, nakon više od deset godina istraživanja steriliteta.
Ova revolucionarna metoda kod nas je dostupna u Specijalnoj ginekološkoj bolnici ,,Genesis” u Novom Sadu.
Ova revolucionarna metoda kod nas je dostupna u Specijalnoj ginekološkoj bolnici ,,Genesis” u Novom Sadu.

– Pomoću ERA testa sada znamo da je jedan od uzroka za neuspjeh vantjelesne oplodnje i neadekvatna perceptilnost sluznice materice za usađivanje embriona. Po prvi put, prije započinja postupka vještačke oplodnje, sada možemo da preciziramo i vrijeme i dan kada je endometrijum žene perceptilan za usađivanje embriona, objašnjava dr Zorica Crnogorac -Ilić, vodeći stručnjak za vantjelesnu oplodnju u Srbiji.
Ovim testom je otkriveno i da kod 25 odsto žena endometrijum nije spreman za prihvatanje embriona treći ili peti dan nakon fertilizacije.
– Nakon odgovarajuće pripreme pacijentkinje hormonskim tabletama, za dijagnostiku je potrebna biopsija endometrijuma, tj. sluznice materice. Uzet uzorak se šalje u IGENOMIX laboratoriju u Valensiju, gdje se vrši genetska dijagnostika bioptata i određuje njegova perceptilnost. Na osnovu dobijenih rezultata se određuje i dan kada će se obaviti postupak transfera embriona. Ukoliko se analizom utvrdi da endometrijum nije prijemčiv, radi se sekundarna biopsija- kaže dr Crnogorac-Ilić.
Više o ovoj savremenoj metodi možete saznati ovdje:
http://www.genesisivfns.com/home/vantelesna-oplodnja-ivf/era-test-endometrijalne-prijemcivosti/


